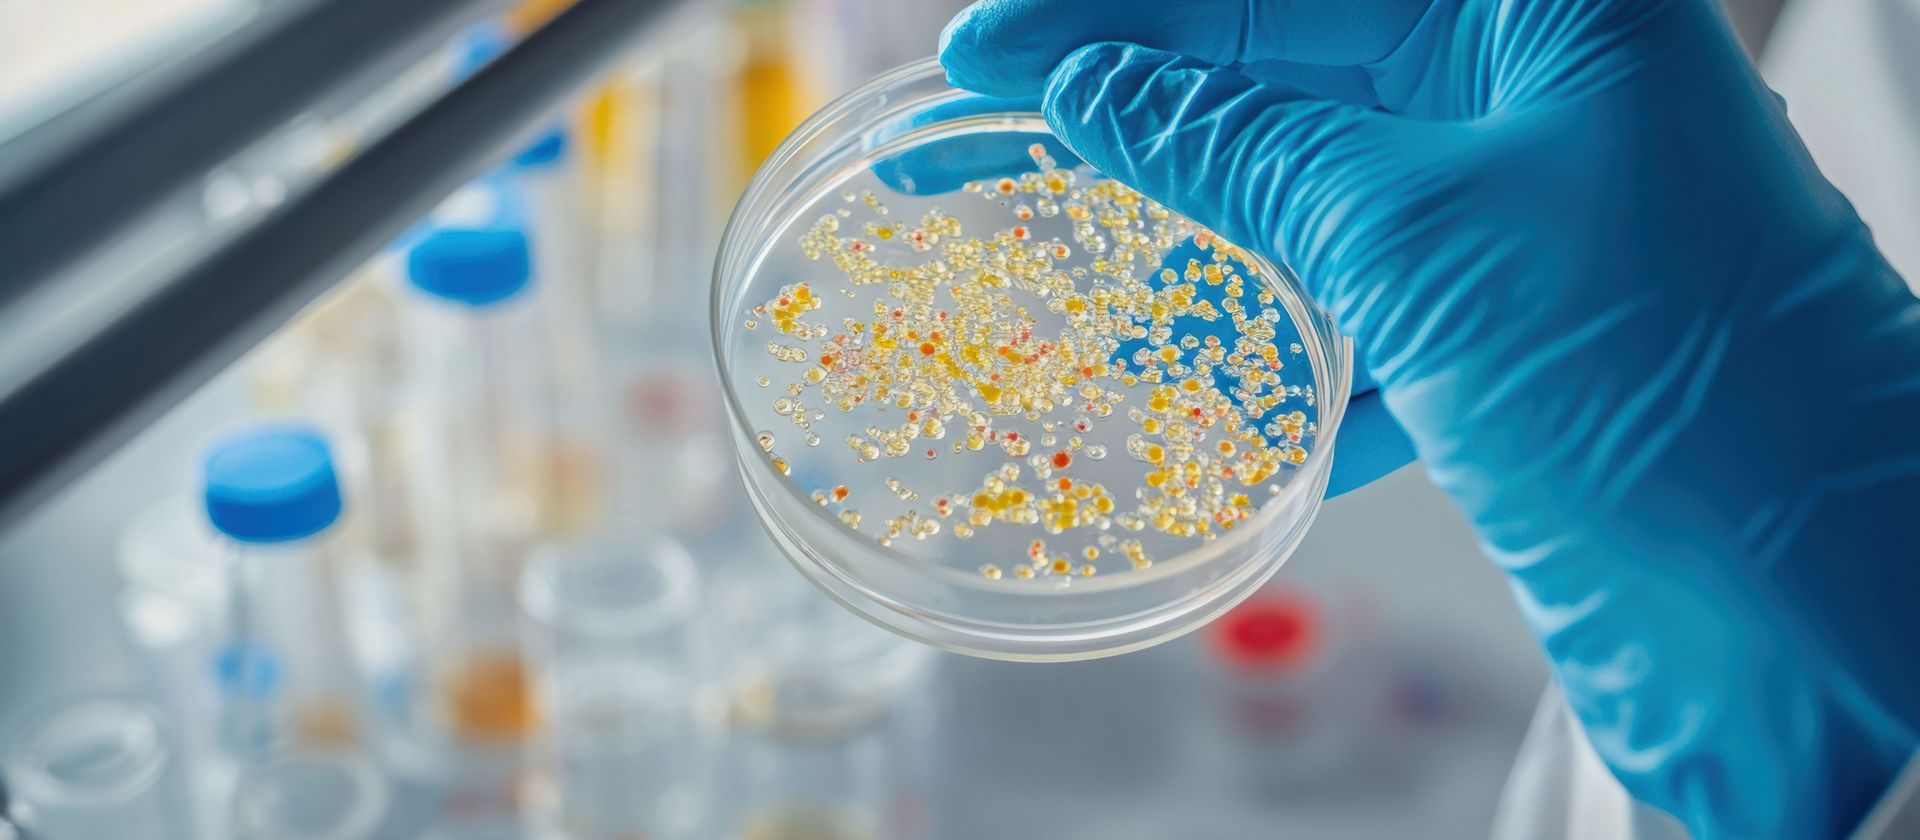

Saarbrücken, 20. November 2024 – Antibakterielle Medikamente sind wichtig, um Infektionen zu behandeln. Da Bakterien jedoch zunehmend resistent gegen aktuelle Medikamente werden, sodass diese nicht mehr oder nur noch eingeschränkt wirken, werden dringend neue Wirkstoffe benötigt. Aufbauend auf früheren Arbeiten konnten Forschende des Helmholtz-Instituts für Pharmazeutische Forschung Saarland (HIPS) zusammen mit einem internationalen Team von Kooperationspartnern eine potenzielle antibakterielle Behandlungsmöglichkeit aufzeigen. Im Fokus steht dabei ein optimiertes Derivat des bakteriellen Naturstoffs Darobactin. Mithilfe mehrerer in vivo-Modelle konnte das Team erfolgreich die Wirksamkeit der getesteten Verbindungen gegen Escherichia coli und Acinetobacter baumannii bestätigen –zwei Keime, von denen bekannt ist, dass sie häufig Arzneimittelresistenzen entwickeln. Ihre Ergebnisse veröffentlichten die Forschenden während der World Antimicrobial Resistance (AMR) Awareness Week der Weltgesundheitsorganisation WHO vom 18. bis 24. November 2024 in der Fachzeitschrift ACS Infectious Diseases.
Im Jahr 2024 aktualisierte die Weltgesundheitsorganisation ihre Liste der Krankheitserreger, bei denen Antibiotikaresistenzen eine besondere Herausforderung darstellen. Diese beinhaltet nun unter anderem die Keime E. coli, A. baumannii und Pseudomonas aeruginosa. Obwohl neue Antibiotika, die auf diese problematischen Krankheitserreger abzielen, dringend benötigt werden, befinden sich kaum neue Wirkstoffkandidaten in der (prä-)klinischen Entwicklung. Ein potenzieller resistenzbrechender Wirkstoff ist Darobactin, ein Antibiotikum auf Basis eines Naturstoffes aus Bakterien, der 2019 erstmals von Forschenden in den USA entdeckt wurde. Darobactin bindet an ein essenzielles Protein in der Zellwand von Bakterien und führt schließlich zu deren Tod. Zuvor hatten Rolf Müller, Jennifer Herrmann und Kollegen festgestellt, dass gentechnisch veränderte Versionen von Darobactinen eine hervorragende antibakterielle Wirkung haben. Insbesondere das nicht-natürliche Darobactin-Derivat D22 hemmte das Wachstum aller oben genannten Problemkeime in Laborversuchen.
Für die aktuelle Studie testete ein internationales Team unter der Leitung von Rolf Müller und Jennifer Herrmann den entwickelten Wirkstoff gegen Infektionen mit unterschiedlichen bakteriellen Erregern. Bei Zebrafisch-Embryonen konnte durch die Behandlung mit D22 eine Infektion mit A. baumannii genauso wirksam beseitigt werden wie durch Ciprofloxacin, ein Breitbandantibiotikum, das bei komplizierten Infektionen eingesetzt wird. Anschließend führten die Forschenden eine Reihe von Wirksamkeits- und Dosierungsversuchen im Mausmodell durch:
- Beste Verabreichungsmethode: Die Studie ergab, dass die Verabreichung von D22 als Injektion effektiver war als eine orale Verabreichung.
- Wirksamkeit gegen P. aeruginosa: Eine wiederholte Verabreichung von D22 schränkte das Wachstum von P. aeruginosa-Bakterien bei Mäusen (Infektion des Oberschenkels) erheblich ein, konnte die Infektion jedoch nicht vollständig beseitigen.
- Mehrfachdosierung bei Infektionen mit E. coli: Die viermalige Verabreichung von D22 innerhalb von 25 Stunden führte bei einem Modell für eine schwere Peritonitis zu einer vollständigen Beseitigung von E. coli. Auch bei Einzeldosen wurde eine sehr gute Wirkung beobachtet. D22-Injektionen über drei Tage (zweimal täglich) reduzierten die Bakterienlast bei einer komplizierten E. coli-Harnwegsinfektion signifikant, wenn auch nicht ganz so stark wie das Antibiotikum Gentamicin, das die Bakterienlast bis unter die Nachweisgrenze reduzierte.
Diese Ergebnisse zeigen, wie D22 kritische Infektionen bekämpfen kann, und sie unterstreichen das Potenzial des Wirkstoffs für die weitere Entwicklung im Hinblick auf zukünftige klinische Studien als „innovative Lösung zur Bekämpfung der Antibiotikaresistenz“, sagen die Autor:innen der Studie.
Die Studie wurde durch den Impuls- und Vernetzungsfonds der Helmholtz-Gemeinschaft gefördert.
Einige der Autor:innen sind Mitarbeitende von Evotec, einem Biotechnologieunternehmen, das sich mit der Erforschung und Entwicklung von Arzneimitteln befasst.
OriginalpubliKation:
Andreas M. Kany, Franziska Fries, Carsten E. Seyfert, Christoph Porten, Selina Deckarm, María Chacón Ortiz, Nelly Dubarry, Swapna Vaddi, Miriam Große, Steffen Bernecker, Birthe Sandargo, Alison V. Müller, Eric Bacqué, Marc Stadler, Jennifer Herrmann, Rolf Müller. In Vivo Activity Profiling of Biosynthetic Darobactin D22 Against Critical Gram-Negative Pathogens. ACS Infectious Diseases (2024) DOI: 10.1021/acsinfecdis.4c00687

![[Translate to German:] Alexandra K. Kiemer, Simon Both, Martin Empting](/fileadmin/HIPS/__processed__/c/6/csm_Kiemer_Both_Empting_7700535100.jpg)
















![[Translate to English:] Illustration](/fileadmin/HIPS/__processed__/b/6/csm_WebNews_DataLeakage_53fd0ef4a5.png)


































![[Translate to German:] [Translate to German:]](/fileadmin/HIPS/__processed__/c/9/csm_HZI_wiss_hemmhof_mik_001_611abc3df4.jpg)




![[Translate to German:] [Translate to German:]](/fileadmin/HIPS/__processed__/1/b/csm_Andreas_Keller_2023_org_029c5088c1.jpg)

![[Translate to German:] [Translate to German:]](/fileadmin/HIPS/__processed__/b/3/csm_AufDiePlaetze_WID-8615_4ee837e55b.jpg)

![[Translate to German:] Künstliche Intelligenz unterstützt die Entdeckung von Arzneimitteln aus Naturstoffen](/fileadmin/HIOH/News/AI_in_NP_Drug_Discovery_AdobeStock.jpg)
































![[Translate to Deutsch:] [Translate to Deutsch:]](/fileadmin/HIPS/__processed__/2/b/csm_HZI_wiss_pseudomonas_cpi_hzi_001_62730ae12d.jpg)

















